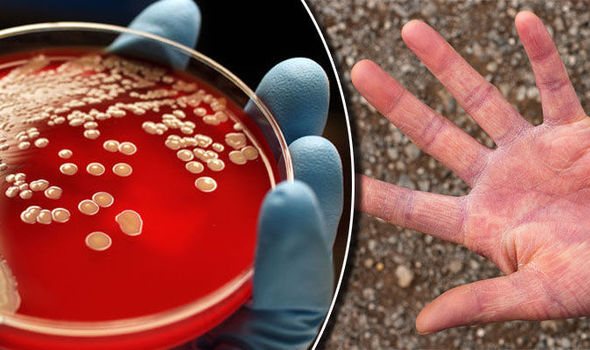
Золотистый стафилококк

Золотистый стафилококк — наиболее опасная и распространенная разновидность инфекции, с которой приходится сталкиваться человеку на протяжении всей жизни. Не существует ни одного внутреннего органа, куда не смог бы пробраться патоген. А самое печальное то, что основным местом обитания золотистого стафилококка являются больницы. И чем больше применяется гигиенических мер защиты, тем сильнее становится инфекция, так как она со временем вырабатывает толерантность к ним. Поэтому стоит разобраться, опасен ли золотистый стафилококк для окружающих, какие заболевания вызывает и какие лекарства помогают с ним бороться.
Особенность патогена
Золотистый стафилококк — грамположительные бактерии округлой формы, которые обитают на кожных и слизистых оболочках человека. При выращивании в специальной среде образуют колонии золотистого цвета, что и дало название данной разновидности патогенов.
Обнаружить золотистый стафилококк можно у каждого здорового человека. При этом большая часть бактерий (около 70-90 %) присутствует в дыхательных путях, ротовой полости и органах слуха. В меньшей степени микроорганизм находится в кишечнике, на коже и половых органах. Но при отсутствии благоприятных условий для размножения золотистый стафилококк мирно сосуществует с человеком, не вызывая развитие опасных заболеваний. Именно поэтому данный микроорганизм относится к условно-патогенной микрофлоре.
Но при сочетании всех условий для размножения спящий патоген приходит в действие, что грозит серьезными осложнениями для здоровья. Золотистый стафилококк опасен для окружающих тем, что он является основной причиной гнойных процессов и бактериального воспаления, так как вырабатывает токсины, которые угнетают нормальную жизнедеятельность клеток организма.
Это может выражаться незначительными кожными высыпаниями, а может способствовать развитию смертельно опасного сепсиса. По статистике, данный патоген провоцирует развитие более ста различных заболеваний. Согласно этим данным можно судить, опасен ли золотистый стафилококк для окружающих или нет.
Его главной особенностью является то, что он постоянно мутирует и учится не реагировать на действие антибиотиков. Устойчивость золотистого стафилококка к лекарственной группе пенициллина достигает 90 %.
Кроме того, микроорганизм не восприимчив к высоким температурам, воздействию прямых солнечных лучей, этиловому спирту (100 %), перекиси водорода.


Врачи отмечают, что золотистый стафилококк может быть обнаружен в различных биологических материалах, таких как кал, нос, горло и кишечник. Симптомы инфекции варьируются в зависимости от места локализации. При наличии стафилококка в носу и горле пациенты могут испытывать боль в горле, затрудненное дыхание и выделения из носа. В кишечнике инфекция может проявляться диареей, болями в животе и тошнотой. Врачи выделяют несколько степеней заражения: от бессимптомного носительства до тяжелых форм, требующих госпитализации. Лечение обычно включает антибиотики, однако выбор препарата зависит от чувствительности штамма. Важно также учитывать, что самолечение может привести к осложнениям, поэтому консультация с врачом является необходимой. Профилактика включает соблюдение гигиенических норм и укрепление иммунной системы.
Чем опасен золотистый стафилококк у взрослых и детей?
В процессе своей активности патоген вырабатывает опасные для здоровья человека токсины.
Основные виды вредных веществ, вырабатываемых патогеном:
- Вещества, повреждающие мембрану. Связываются с рецепторами клеточной мембраны, образуют канал, через который беспрепятственно проводят вредоносные ионы и молекулы. В итоге это приводит к набуханию и последующему разрыву клетки.
- Эксфолиативные компоненты. Они являются основным возбудителем пузырчатки у новорожденных и скарлатиноподобной сыпи.
- Экзотоксины. Способствуют развитию синдрома токсического шока, вызывают лихорадку, снижение кровяного давления, дисфункцию почек и снижают концентрацию лейкоцитов в крови.
- Истинный лейкоцидин. Оказывает разрушительное действие на лейкоциты.
- Экзотоксины. Провоцируют развитие кожной и респираторной аллергии. Это выражается в различных дерматитах и бронхиальной астме.
- Белки. Их функция заключается в подавлении процессов фагоцитоза, что препятствует организму человека ввести активную борьбу с вредоносными микроорганизмами. Снижая функцию Т- и В-лимфоцитов, они тем самым уменьшают эффективность защитной реакции организма, что негативно отражается на здоровье.

Чем опасен золотистый стафилококк в горле?
Появление золотистого стафилококка в горле является основным провоцирующим фактором развития ангины, фарингита, ларингита, тонзиллита, бронхита. При этом на слизистой образуются различные гнойные язвы и эрозии, что значительно усложняет лечение патологии. При запущенной форме заболевания многочисленные гнойные наложения и некротические участки подлежат удалению хирургическим путем.
Присутствие бактерии в горле представляет угрозу для всего организма, так как при ее прогрессировании инфекция продвигается дальше и захватывает все прилегающие органы и ткани, что значительно осложняет ситуацию.
Поэтому, зная, чем опасен золотистый стафилококк в горле, следует уделять особое внимание своему здоровью и вовремя проводить лечение заболеваний.
Основные признаки поражения горла:
- першение;
- осиплость голоса;
- боль при глотании;
- мокрота при откашливании с примесями гноя;
- повышенная сухость во рту;
- воспаление шейных лимфоузлов.
Золотистый стафилококк — это бактерия, которая может обитать в организме человека, вызывая различные заболевания. Многие люди отмечают, что при наличии стафилококка в носу, горле или кишечнике могут возникать такие симптомы, как боль в горле, кашель, а также расстройства пищеварения, включая диарею и боли в животе. Важно понимать, что степень заражения может варьироваться: от бессимптомного носительства до тяжелых инфекций, требующих медицинского вмешательства. Лечение обычно включает антибиотики, однако устойчивость некоторых штаммов к препаратам делает терапию сложной. Поэтому важно своевременно обращаться к врачу при появлении подозрительных симптомов и не заниматься самолечением. Профилактика включает соблюдение гигиенических норм и укрепление иммунной системы.
Золотистый стафилококк лечение антибиотиками
Стафилококк — Истоки чистоты, Renaissance Triple Set, Лимфосан базовый, Essentials. Эхинацея и цинк, Эпам-7, Эпам-900, Гранатовый бальзам, Серебряный бальзам, Адаптовит, Новомин, Элемвитал с органическим цинком, Синхровитал 5, Ритмы здоровья
При регистрации в корпорации «Сибирское Здоровье» в качестве Консультанта на официальном сайте Корпорации по этой ссылке, вы можете покупать продукцию с 25% возвратом на свой счет на следующий день. Хотите узнать все возможности корпорации, жмите сюда
Стафилококк в горле у ребенка или взрослого — это наличие бактерий рода Staphylococcaceae на слизистом эпителии ротоносоглотки. Большая часть бактерий данного рода входят в число условно-патогенных микроорганизмов, то есть вызывают заболевания только при наличии благоприятных условий ослабление иммунитета, переохлаждение, гормональный сбой и т. Существует много разновидностей стафилококков, но самым опасным из них считается золотистый aureus.
Поэтому если говорят, что в ротоносоглотке обнаружен стафилококк, то имеют ввиду именно золотистый. Учитывая вредность данной бактерии, в данной теме мы хотим подробно разобрать, что представляет собой стафилококковая инфекция в горле и носе, как она проявляется и выглядит на фото, а также как вылечить ее традиционными и народными средствами.
В окружающей среде обитает множество патогенных и непатогенных микроорганизмов, причем часть из них живет на нашей коже. Сразу после рождения ребенок стерильный, но в первые же минуты жизни кожные покровы, пищеварительный тракт и дыхательные пути малыша заселяются различной микрофлорой, в основном той, которая присутствует у его матери.
Рассмотрим более подробно пути заражения золотистым стафилококком. Также существует такое понятие, как аутоинфекция, — переход бессимптомного носительства в заболевание под воздействием таких неблагоприятных факторов, как:. Как видите, путей заражения золотистым стафилококком очень много, но избежать инфицирования можно, соблюдая правила личной гиены, ведя здоровый образ жизни и поддерживая иммунитет.
Течение стафилококковой инфекции горла может быть бессимптомным, но она может протекать и в форме воспаления верхних дыхательных путей, а именно:.
Каждая из перечисленных форм проявляется отдельным симптомокомплексом, причем симптомы у взрослых имеют менее выраженный характер, чем у детей. Фарингит, вызванный золотистым стафилококком, проявляется такими симптомами, как:.
Наличие стафилококков в верхних дыхательных путях несет угрозу для здоровья. Это связано с тем, что такие неблагоприятные факторы, как снижение иммунитета, переохлаждение, стресс, обострение хронической патологии, могут вызвать развитие инфекционного процесса.
При активизации стафилококковой инфекции существует риск распространения инфекционного процесса на нижние дыхательные пути с развитием бронхита и пневмонии.
Кроме того, стафилококк способствует обострению таких хронических болезней, как сахарный диабет, ревматоидный артрит, пиелонефрит. Также данный микроб ослабляет устойчивость к другим патогенным микроорганизмам, например, стрептококкам или пневмококкам. Самым опасным осложнением стафилококковой инфекции является попадание возбудителя в кровь с развитием сепсиса. Подобные последствия у взрослого или ребенка появляются, если несвоевременно или неправильно лечить золотистый стафилококк в горле.
Поэтому при наличии вышеописанных симптомов не стоит заниматься самолечением, а следует обратиться к специалистам — врачу-отоларингологу или врачу-инфекционисту, которые назначат адекватную терапию.
Симптомы стафилококков в ротоносоглотке не являются специфическими, поэтому нельзя ставить диагноз о наличии стафилококковой инфекции, опираясь только на субъективные и объективные признаки. Поэтому начинают лечить стафилококк в горле только после того, как будет идентифицирован возбудитель лабораторно.
С этой целью сегодня применяется бактериоскопический, бактериологический и серологический методы. Самым доступным методом диагностики стафилококковой инфекции является мазок из ротоносоглотки.
Полученный материал исследуют под микроскопом, после чего высевают на питательную среду, чтобы получить колонии бактерий. При наличии стафилококка через сутки после посева на среде появляются выпуклые колонии бактерий белого, желтого или оранжевого цвета. При серологическом исследовании используются бактериофаги, разделенные на четыре группы. При положительном серологическом тесте стафилококк убивает одну или несколько групп бактериофагов.
Данный метод не такой точный, как микробиологический, поэтому применяется редко. Говоря о норме, следует помнить, что стафилококки бывают разными. Условно патогенные стафилококки могут присутствовать в организме человека, а от патогенных представителей этого рода золотистый, эпидермальный и сапрофитный лучше избавиться. Поэтому в норме допускается количество стафилококков, кроме золотистого, не более 10 во второй степени.
Большинство специалистов считают, что в норме в ротоносоглотке золотистого стафилококка не должно быть, особенно у детей и лиц с ослабленным иммунитетом. В то же время другая часть врачей, в частности Комаровский, настаивают на том, что нужно лечить больного, а не результаты анализов. То есть лечение назначается при наличии клинической симптоматики стафилококковой инфекции, а не при бессимптомном течении и положительном посеве на стафилококк.
Стафилококка в горле лечение должно назначаться исключительно специалистом, поскольку неадекватная терапия может привести к развитию устойчивости данной бактерии к противомикробным средствам. Важным компонентом лечения стафилококковой инфекции является применение иммуномодуляторов.
Для этого могут применяться следующие иммуностимуляторы:. Прием перечисленных препаратов проводится в течение острого периода стафилококковой инфекции и на протяжении месяца после утихания симптомов. Важно понимать, что вылечить стафилококк только с помощью народных средств нельзя. Народные методы могут эффективно дополнить традиционную терапию, облегча симптомы заболевания и ускоряя выздоровление.
Локальная борьба со стафилококком заключается в полоскании горла и рассасывании леденцов, которые содержат антисептики. Специалисты рекомендуют полоскать горло такими средствами, как Хлорофиллипт, Тантум Верде, Хлоргексидин, Мирамистин или Гексорал, поскольку они обладают наивысшей эффективностью по отношению к золотистому стафилококку.
Перечисленные антисептики обладают противомикробным, противовоспалительным и восстанавливающим действиями, что позволяет уменьшить выраженность симптомов инфекции, ускорить выздоровление и предотвратить развитие серьезных осложнений. Хлорофиллипт обладает противомикробным, противовоспалительным, болеутоляющим и заживляющим действиями, эффективно при полоскании уничтожает стафилококк и стрептококк в ротоносоглотке. Кратность полосканий должна быть не менее четырех раз в день.
Препарат практически не имеет противопоказаний и побочных эффектов, поэтому может применяться во время беременности, грудного вскармливания, а также у детей. Единственным противопоказанием к препарату является непереносимость его компонентом, поэтому перед лечением все-таки необходимо проконсультироваться с лечащим доктором. Также бороться со стафилококком можно с помощью леденцов, которые содержат антисептики.
Наиболее эффективными сегодня считаются такие средства, как Фарингосепт, Стрепсилс, Декатилен и Граммидин. Контрольный мазок из горла и посев материала для определения стафилококков проводят через 4 недели после окончания курса лечения. Таким образом, основываясь на вышесказанном, можно сделать вывод, что золотистый стафилококк в горле не должен определяться, поскольку эта бактерия является истинно патогенным микроорганизмом, который может вызывать заболевания, опасные для здоровья и даже жизни человека.
В настоящее время известно 27 разновидностей этих бактерий, при этом 14 из них всегда находятся на кожных или слизистых покровах человека. Достаточно часто встречается стафилококк в носу и горле. Лечение при этом должно быть комплексным. Но важно обращать внимание не на сам факт присутствия этих микроорганизмов, а на их концентрацию. Также необходимо смотреть, какой именно вид стафилококков наиболее активен.
Помимо этого, указанный микроорганизм всегда находится в кишечнике. При диагностике необходимо смотреть на выявленное количество бактерий. При развитии стафилококковой инфекции в горле возможно появление таких заболеваний, как ангина, гингивит, стоматит и прочие. Чрезмерное количество бактерий в носу приводит к его заложенности, постоянному насморку. Также такое поражение может характеризоваться общим недомоганием. Во многих случаях люди даже не знают, что у них стафилококк.
Отзывы обычных пациентов свидетельствуют о том, что лишь после специальных обследований удалось выявить эту бактерию. Но при этом существуют определенные внешние признаки, свидетельствующие о том, что в организме развивается стафилококковая инфекция. К таким проявлениям относятся:.
Предлагаем ознакомиться Стафилококк у новорожденных и грудных детей: симптомы, лечение
При этом не обязательно должны быть все симптомы, чтобы заподозрить, что появился стафилококк в носу и горле. Лечение при этом должно назначаться после проведения обследования. В ряде случаев заболевание может быть бессимптомным. Но не всегда это означает, что нет проблем. Например, при обнаружении золотистого стафилококка лечение будет обязательным. Понять, что у вас начала развиваться стафилококковая инфекция, можно по ряду признаков.
Но в большинстве случаев люди и не подозревают, что у них не просто затяжной насморк, а поражение бактерией стафилококк. Фото этого микроорганизма, который похож на гроздь винограда, не передает всей опасности. Если анализ на стафилококк показал, что микроорганизм поразил горло, то при этом могут присутствовать такие симптомы:. Одним из самых опасных считается золотистый стафилококк.
Чем грозит развитие золотистого стафилококка в носу?
Носовые пазухи являются наиболее распространенным местом обитания золотистого стафилококка. Зачастую он бессимптомно существует там на протяжении длительного периода, но при возникновении провоцирующего фактора в виде переохлаждения, ОРВИ, бесконтрольного применения сосудосуживающих капель активно размножается и способствует развитию острой формы ринита.
Чем опасен золотистый стафилококк в носу? При отсутствии адекватного лечения возбудитель распространяется дальше и способен вызывать синусит, гайморит, фронтит.
Характерные признаки поражения носа:
- быстроразвивающийся насморк;
- выделения изначально прозрачные, а затем становятся гнойными;
- голос приобретает осиплость и гнусавость;
- обоняние пропадает;
- затрудненное дыхание.
В ухе
При попадании золотистого стафилококка и формировании благоприятной среды для его размножения развивается отит. Вот чем опасен золотистый стафилококк в ухе.
Характерные симптомы поражения:
- заложенность уха;
- зуд;
- болезненность в наружном слуховом проходе;
- ушные гнойные выделения.
При отсутствии адекватного лечения инфекция распространяется дальше и способна привести к поражению оболочки головного мозга, костной ткани и вызывать частичную или полную потерю слуха.
В кишечнике
Подселение золотистого стафилококка в кишечник провоцирует развитие воспалительных процессов. Чем опасен золотистый стафилококк в кишечнике?Активное размножение микроорганизмов может спровоцировать пищевое отравление, которое ослабит иммунную систему организма.
Вследствие этого инфекция способствует развитию гастроэнтерита, симптомы которого появляются уже в первые сутки развития.
Характерные признаки:
- обильная рвота;
- головокружение;
- кровяные примеси в фекалиях;
- продолжительная диарея;
- тошнота;
- судороги брюшных мышц.
Форма развития заболевания может варьироваться от легкой до крайне тяжелой. При этом повышается риск сильной потери жидкости организмом на фоне обильной рвоты и диареи. Поэтому важно соблюдать водный режим, так как значительная потеря влаги может быть смертельно опасной для человека.
У детей
Для детей вредоносный микроорганизм представляет повышенную опасность, так как иммунная система ребенка не до конца сформирована и не имеет возможности полноценно противостоять данному агенту. В результате этого патоген способен беспрепятственно распространяться по всему организму, негативно влияя на рост и развитие малыша.
Чем опасен золотистый стафилококк у детей? При поражении кожных покровов возможно образование опрелости, фурункулов, карбункулов, потницы, дерматитов. Но самым опасным последствием стафилококкового поражения является синдром токсического шока, который может привести к полной дисфункции почек ребенка.
Антибиотики от стафилококка назначаются при явных признаках инфекции и только лечащим врачом, ведь самовольный прием сопряжен с осложнениями. Антибиотики при золотистом стафилококке у.
Золотистый стафилококк Staphylococcus aureus — представитель нормальной микрофлоры организма, который при благоприятных условиях ослабление иммунитета, открытые раны способен вызвать сильнейший воспалительный процесс абсолютно во всех тканях и органах. Он широко распространен, изменчив, обладает высокой выживаемостью, антибиотикорезистентностью и быстро приспосабливается к разным условиям среды.
У беременных
В группу риска также входят беременные женщины, так как в период вынашивания плода их иммунная система на фоне гормонального сбоя частично теряет свои защитные функции.
Опасен ли золотистый стафилококк для беременной женщины? Патоген способен беспрепятственно преодолевать плацентарный барьер, что приводит к поражению околоплодных оболочек и самого плода. В большинстве случаев это заканчивается выкидышем.
При обнаружении стафилококка во влагалище беременной женщины лечение проводится в обязательном порядке, даже при отсутствии признаков воспаления. Это необходимо для того, чтобы ребенок во время прохождения родовых путей не смог заразиться инфекцией.
Полезные продукты при стафилококке
Специальной диеты при стафилококке не предусмотрено, но следует придерживаться принципов питания при инфекционных заболеваниях. Так как при острых формах стафилококка происходит интоксикация организма продуктами жизнедеятельности возбудителей, могут изменяться отдельные функции органов, нарушается энергетический обмен организма (повышается уровень энерготрат), белковый обмен (происходит усиленный распада белков), водно-солевого обмена (потеря минеральных солей и жидкости), снижается уровень витаминов в организме. Рацион питания должен обеспечить необходимое количество энергии и пищевых веществ, чтобы обеспечить нормальное функционирования как организма в целом, так и его защитных функций. Поэтому диета должна включать в себя легкоусвояемые продукты и блюда (например, диета №13) и предусматривать частое употребление пищи, небольшими порциями.
К рекомендуемым продуктам относятся:
- белковые продукты (суточная норма – 80 грамма белка, из которого только 65 % животного происхождения): протертые паровые мясные блюда, отварная рыба, яйца (всмятку, паровые омлеты, суфле), ацидофилин, творог, кефир, простокваша, сливки, сливочное масло, оливковое масло, сметана, рафинированное растительное масло;
- продукты с углеводами (суточная норма – 300 грамм: 2/3 сложные углеводы: каши, картофель, макароны; 1/3 легкоусвояемые углеводы: желе, муссы, мед, варенье);
- продукты, которые являются источниками пищевых волокон (овощи, фрукты, ягоды);
- обильное питье (чая с молоком, лимоном, морсы, отвара шиповника, кисель, компоты, соки, нежирные кисломолочные напитки, столовые минеральные воды);
- продукты, которые повышают аппетит (кисломолочные напитки, нежирные рыбные, мясные бульоны, кисло-сладкие соки ягод и фруктов, разбавленные водой, томатный сок);
- продукты богатые витаминами А, В, С (например: тыква, морковь, сладкий перец, брокколи, шпинат, зелень петрушки, кедровые и грецкие орехи, тунец, облепиха).
В период выздоровления можно использовать диету № 2 (с умеренной стимуляцией пищеварительного тракта), а после выздоровления – диету № 15 ( рациональное питание).
Опасность патологии для грудничка
Из-за широкого распространения микроба встреча с ним может произойти уже в первые дни жизни ребенка. Поэтому стоит разобраться, чем опасен золотистый стафилококк у грудничка, чтобы оценить степень опасности инфекции.
Чаще всего патоген провоцирует развитие следующих патологий у малыша:
- Пузырчатка. Характеризуется образованием пузырьков на коже, наполненных гноем. Пораженные участки вызывают болезненность, что негативно отражается на самочувствии ребенка.
- Болезнь Риттера, или синдром ошпаренной кожи. Характеризуется обширными участками поражения на теле, что приводит к отслаиванию верхнего слоя эпидермиса.
Общие симптомы
Характерные признаки поражения золотистым стафилококком отличаются в зависимости от вида заболевания, которое он вызывает. Но существуют и общие симптомы, которые помогают распознать патологический процесс на начальной стадии развития:
- Местное повышение температуры тела. Именно этот признак позволяет точно определить, какой именно орган подвергся поражению золотистым стафилококком. Повышение температуры на отдельном участке тела является ответом организма на внедрение патогена с целью не допустить его дальнейшее распространение.
- Гиперемия инфицированных участков. Образуется вследствие активного прилива крови к месту воспаления. При этом сосуды расширяются, а отток венозной крови сокращается. Таким образом организм пытается повысить приток кислорода к проблемному участку с целью нейтрализации токсического действия бактерии.
- Нарушение функциональности отдельных тканей и органов вследствие их повреждения на клеточном уровне.
- Болезненность при ощупывании. Данный симптом обусловлен сдавливанием нервных окончаний прилегающими отечными тканями. Боль может быть вызвана также избыточным притоком крови к воспаленному участку.
- Отечность тканей. Этот симптом развивается вследствие повышения проницаемости кровяных сосудов.
Общие симптомы поражения организма золотистым стафилококком могут отличаться у взрослых и детей. Поэтому установить диагноз и причину воспаления может только опытный специалист.
Пути заражения
Инфекция может проникать в организм при повреждении целостности слизистой оболочки и кожных покровов, так как она является неотъемлемой частью микрофлоры человека. Заразиться золотистым стафилококком можно также с некачественными продуктами питания и при тесном контакте с носителем бактерии.
Специалисты выделяют несколько основных путей передачи бактерии:
- Контактно-бытовой. В этом случае заразиться можно при использовании чужого полотенца или других предметов личного пользования. Причем инфекция может спровоцировать гнойный процесс или внедриться в организм, что сделает человека ее переносчиком.
- Воздушно-капельный. Больной человек при кашле, чиханье и просто дыхании выделяет бактерию в воздух, при этом она может попасть в дыхательные пути рядом находящегося.
- Артифициальный способ. Инфекция попадает в организм через недостаточно обработанные медицинские инструменты. Но зачастую бывает, что необходимые предметы были дезинфицированы в привычном режиме, а мутирующий вид золотистого стафилококка успел выработать устойчивость к действию дезпрепаратов.
- Фекально-оральный. Выделение инфекции происходит через рвотные массы или с фекалиями. При этом инфицирование здорового человека может произойти при несоблюдении гигиены больным человеком, у которого на руках могут присутствовать бактерии, и при рукопожатии бактерия распространяется дальше.
- Воздушно-пылевой. Золотистый стафилококк способен длительное время сохранять свою жизнеспособность в окружающей среде, и в частности в пыли. Поэтому при вдыхании этих микрочастиц происходит инфицирование.
Общие сведения о стафилококке
Источником распространения инфекционного агента являются больные и носители патогенных штаммов. Особую опасность для окружающих представляют пациенты с и открытыми очагами гнойного воспаления. Возбудитель передается воздушно-капельным, контактно-бытовым и алиметарным путем. Дети дошкольного чаще всего заражаются, употребляя в пищу обсемененные продукты питания и при контакте с больными сверстниками.
К группе заболеваний, объединенных термином «стафилококковая инфекция» относятся гнойничковые воспаления кожных покровов, нарушения пищеварения в кишечнике, патологии ЛОР-органов, воспаления костной ткани и т.д. Инфекционный агент может быть обнаружен в анализах крови, фекалий и соскобов с поверхности кожи.
Не все разновидности стафилококков представляют серьезную угрозу взрослым и детям. Более того, часто патогенные кокки этого семейства не могут причинить серьезный вред ребенку. Например, присутствие бактерий на слизистых оболочках горла не приводит к тяжелым последствиям, если у малыша достаточно высокий уровень .
Наибольшую опасность представляет собой , особенно – при активной фазе заболевания у грудных младенцев. Относительно высокая заболеваемость среди новорожденных обусловлена тем, что в начале жизни у ребенка не синтезируется иммуноглобулин IgА, во многом определяющий уровень местного иммунитета.
Обратите внимание: золотистый стафилококк получил свое название благодаря способности бактерий синтезировать пигмент, окрашивающий колонии, поселяющиеся на твердых питательных средах, в характерный золотистый или оранжевый цвет.
Осложнения и последствия
Чтобы понять уровень опасности, следует разобраться, чем опасен для человека золотистый стафилококк при отсутствии своевременного и адекватного лечения:
- Менингит. В данном случае вредоносный патоген провоцирует гнойное воспаление оболочки головного мозга. Патологический процесс сопровождается высокой температурой, невыносимой головной болью, тошнотой, судорогами, рвотой. Летальный исход возможен даже при своевременно начатой терапии. Уровень смертности составляет 30 % из всех диагностируемых случаев.
- Заражение крови. Патологический процесс развивается вследствие попадания инфекции в кровь с последующей активной выработкой токсинов. Стафилококковый сепсис является смертельно опасным заболеванием. При этом у пациента фиксируется температура тела около 40 градусов, обильная рвота, тошнота, а также дисфункция легких, печени, кишечника, головного мозга. Начатая терапия без предварительно проведенной антибиотикограммы грозит летальным исходом для человека.
- Эндокардит. Заболевание характеризуется поражением клапанов сердца и внутреннего слоя органа. Патология характеризуется тахикардией, суставной болью, снижением работоспособности. Зачастую эндокардит одновременно сочетается с менингитом и сердечной недостаточностью, что значительно усложняет самочувствие больного.
- Синдром токсического шока. Данный патологический процесс является своеобразной шоковой реакцией иммунной системы на внедрение патогена. При этом у больного фиксируется высокая температура тела, обильная рвота, диарея, низкое артериальное давление. Все это в сочетании грозит вероятностью летального исхода.
Исходя из осложнений, которые могут развиваться при внедрении патогена в организм, можно понять, чем опасен золотистый стафилококк в носу, в ротовой полости или любом другом органе. Ведь инфекция способна распространяться по всему организму в максимально короткие сроки, не встречая на своем пути никаких преград.
Народные средства
Народные методы лечения золотистого стафилококка в носу у взрослых применяют для укрепления защитных функций организма, очищения организма от токсинов. В терапии используют отвары, настои и настойки. Но без приема антибиотиков народные средства неэффективны.
Растения с иммуностимулирующим действием:
- соцветия эхинацеи;
- ягоды и цветы шиповника;
- зверобой;
- боярышник.
Травы можно использовать по одной, или готовить сборы из равного количества нескольких ингредиентов. Заварить 1 ст. л. сырья 200 мл кипятка, оставить в закрытой посуде на полчаса. Пить по 100 мл настоя дважды в день.
При частом обострении стафилококковой инфекции смешать в равных частях измельченные корни петрушки и сельдерея. Смесь измельчить в блендере, отжать сок. Пить по 5 мл перед каждым приемом пищи.
При золотистом стафилококке нельзя прогревать область носа, лба и щек, противопоказано посещение бань, горячие ванны.
Тепловые процедуры способствуют распространению инфекции по всему организму. Что опасно развитием тяжелых последствий и осложнений. Следует избегать и переохлаждения головы и всего тела, чтобы еще больше не ослабить иммунную систему.
Обязательно необходимо принимать витаминные комплексы с высоким содержанием аскорбиновой кислоты, ретинола. Укрепить иммунитет поможет мед, абрикосы, черная смородина, лук, чеснок, имбирь. Эти продукты нужно включать в рацион во время лечения, и в период эпидемий простудных заболеваний.
Народные средства для промывания носа
Из лекарственных трав можно приготовить эффективные растворы для промывания носа, очищения от слизи, устранения отечности. Они действуют не хуже аптечных средств, имеют меньше противопоказаний и побочных эффектов. Лечебные настои и отвары несложно приготовить, стоимость сырья доступная.
Рецепты:
- Залить 1 ст. л. сухих соцветий ромашки 250 мл кипятка, томить на водяной бане четверть часа. Остудить в закрытой посуде до комфортной температуры, процедить. Промывать нос 3-5 раз в день, обязательно перед применением любых местных лекарственных препаратов.
- Заварить 220 мл кипятка 2 ст. л. липового цвета, настаивать 3 часа в термосе. Процеженный настой использовать для промывания носовых ходов до 5 раз в день. Средство обладает противовоспалительным, антибактериальным, иммуномодулирующим действием.
- В 1 л воды растворить 5 г соли. Самое простое и эффективное антисептическое средство. Использовать 3-4 раза в день.
В нос можно закапывать свежий сок алоэ — это сильный природный антибиотик. Сок смешать с медом в равных пропорциях. Закапывать по 2-3 капли в каждую ноздрю дважды в день. Продолжительность лечения — 1-2 недели.
Домашние капли можно приготовить из корня лопуха или окопника. Залить 200 мл воды 2 ст. л. сырья, нагревать на водяной бане 20 минут. Остудить, процедить. Закапывать по 5 капель в каждую ноздрю трижды в день.
Диагностика
Для выявления стафилококковой инфекции в организме необходимо прохождение определенных видов исследований. При этом положительный результат анализов не является подтверждением наличия заболевания. Проверка проводится только при появлении характерных патологических симптомов, что свидетельствует о реакции организма на внедрение патогена.
Основные виды исследований:
- мазок из горла, носа в случае поражения верхних дыхательных путей;
- анализ кала при расстройствах кишечника;
- соскоб с кожи при дерматологических заболеваниях;
- анализ крови для исключения или подтверждения заражения;
- анализ мочи при развитии цистита.
Виды стафилококка
Стафилококковый тонзиллит, стафилококковый фарингит и стафилококковый ларингит – каждое из этих заболеваний имеет разные симптомы и рассматривается специалистами отдельно.
- Стафилококковый тонзиллит начинается с повышения температуры до 40 градусов. Наблюдается воспаление миндалин. Миндальные бугорки при этом характеризуются появлением на них гнойных наложений, которые легко снимаются и имеют беловато-желтый оттенок. При тонзиллите возникает боль в горле, которая отдается в висок, в ухо и шею. При попытке резко подняться с постели, человек испытывает головокружение.
- Стафилококковый фарингит возникает нечасто и наблюдается приблизительно в 5% случаев. Характеризуется слущиванием эпителия, образованием концентрации вязкой слизи на задней части глотки. Першение в горле вызывают сухой кашель и осиплость.
- Стафилококковый ларингит возбуждает воспаление слизистой оболочки горла и зачастую затрагивает трахею. В этом случае нередки проявления трахеита. Происходит нарушение тембра голоса, его высоты и силы звучания. Возможна полная потеря голоса. В начальной стадии человека донимает сухой кашель, со временем он переходит во влажный. Во время откашливания, происходит отделение мокроты.
Стафилококковая инфекция в запущенной форме поражает нижние отделы дыхательных путей и проникает в легочную ткань. При этом происходит захват трахеи и бронхов.
При активизации размножения микроорганизмов, принятых называть патогенными, человек способен заработать гнойную ангину.
Стафилококковая ангина поражает кости и суставы, вызывает синдром токсического шока, развитию пневмонии и плевритов. В запущенной форме болезнь может провоцировать появление стафилококкового менингита и, в результате абсцесса головного мозга. Это серьезное наследие от поражения организма стафилококком.
Лечение
Терапия назначается лечащим врачом только после проведенной антибиотикограммы. Это помогает выявить устойчивость патогена к конкретному виду лекарств. При этом необходимо четко придерживаться назначенной схемы течения и принимать препараты не до устранения симптоматики, а не менее 5 дней. Самостоятельно прерывать лечение категорически запрещено.
Основные виды препаратов для лечения стафилококковой инфекции.
- «Амоксициллин». Угнетающе действует на патоген, препятствует его дальнейшему развитию. Препарат блокирует синтез пептидогликана. Прием проводится трижды в день, независимо от еды, по 1 г за один раз.
- «Ванкомицин». Блокирует компонент, входящий в клеточную мембрану инфекции, что вызывает гибель патогена. Препарат вводится внутривенно каждые 6 или 12 часов по усмотрению врача.
- «Цефазолин». Лекарство обладает широким спектром действия. Основная его функция заключается в блокировке выработки компонентов клеточной стенки инфекции. Вводится внутримышечно или внутривенно каждые 3 часа.
- «Оксациллин». Эффективен на поздних стадиях развития патогена. Вводится внутримышечно, внутривенно, орально.
- «Кларитромицин». Препятствует выработке белков вредоносных микроорганизмов. Принимается в виде таблеток, но при тяжелой форме заболевания назначается внутривенно.
Зная, чем опасна инфекция золотистого стафилококка, следует понимать, что любое самолечение грозит серьезными осложнениями для здоровья.
Методы лечения
Заниматься самолечением при возникновении стафилококковой инфекции горла категорически запрещается. Обращаться за врачебной помощью следует сразу же после появления первых симптомов патологии.
Госпитализация при заболевании у детей обязательна, из-за высокого риска развития отека гортани и осложнений. Во взрослом возрасте госпитализация показана только при беременности или тяжелом состоянии.
Чтобы бороться с заболеванием применяют медикаментозные средства, физиотерапию, народное лечение и в крайних случаях – хирургическое вмешательство. Метод терапии подбирается индивидуально лечащим врачом.
Когда сбивать температуру
При стафилококковой инфекции в большинстве случаев у больных происходит повышение температуры до значительных показателей. Ее следует сбивать обязательно. Если же температура не выше 38оС, и больной нормально ее переносит, принимать жаропонижающие средства не требуется.
Медикаментозное
При медикаментозной терапии для устранения заболевания больным назначаются:
- иммуномодуляторы;
- антибиотики (таблетки и инъекции);
- антисептические препараты для местного применения;
- смягчающие полоскания для горла.
Успешно вылечить болезнь можно только при условии, что все препараты будут применяться строго по врачебным предписаниям в рекомендованных дозировках.
Физиотерапия
При болезни показаны разные виды физиотерапии. Местное введение лекарственных препаратов осуществляется под действием электрофореза. Помогает избавиться от инфекции антисептическая обработка глотки ультрафиолетом. При серьезном нарушении кровообращения в тканях, после снятия острого состояния для восстановления нормального кровоснабжения тканей, проводят ультразвуковое лечение или лазерные процедуры.
Хирургическое
Необходимость в хирургическом вмешательстве возникает в том случае, если у больного на фоне стафилококкового поражения происходит серьезное необратимое разрушение миндалин, из-за которого возникают частые рецидивы. В такой ситуации показано удаление гланд.
Может потребоваться операция, если формируется глоточный абсцесс, который необходимо вскрыть для предупреждения появления сепсиса.
Народные средства
При поражении горла ауреусом народные средства применяются только в качестве вспомогательной терапии для облегчения симптоматики.
- Ягоды черной смородины. В свежем или замороженном виде они быстро улучшают состояние больного горла и останавливают размножение возбудителя болезни. В день больному следует съедать их в объеме 1 стакана или более.
- Абрикосы. Их сок обладает аналогичным действием, что и черная смородина. Ежедневно следует потреблять по 8-10 ягод. С их помощью полностью убить патогенов нельзя, но снизить их число удастся.
- Полоскания свекольным соком. Средство обладает мощным антибактериальным действием и позволяет в некоторой степени снять боль. Процедуру проводить ежедневно не менее 3 раз в день.
Народная терапия может применяться только в том случае, если не будет мешать традиционному лечению.
Поделитесь статьей в соц. сетях:
Профилактика
Профилактические мероприятия являются основным методом борьбы с бесконтрольным распространением золотистого стафилококка. Соблюдение несложных правил поможет избежать серьезных проблем со здоровьем.
Основные рекомендации:
- Своевременное устранение воспалительных процессов в организме.
- Соблюдение чистоты в квартире, на рабочем месте.
- Регулярная стирка и глажка одежды.
- Периодическое проветривание помещений.
- Сбалансированное питание.
- Отказ от вредных привычек.
- Регулярные пешие прогулки на свежем воздухе в течение 20-30 минут.
- Соблюдение правил личной гигиены.
- Своевременная обработка ран при нарушении целостности кожи.
- Употребление только чистых и качественных продуктов.
- Не посещать сомнительные учреждения, оказывающие услуги маникюра, татуажа, солярия.
Золотистый стафилококк является неотъемлемой частью микрофлоры человека. И каждый рано или поздно сталкивается с этим патогеном на протяжении своей жизни. Но насколько это будет опасно, зависит от самого человека, так как инфекция не дремлет и при ослаблении иммунитета начинает активно действовать. Поэтому зная, чем опасен золотистый стафилококк, стоит соблюдать несложные профилактические меры, и тогда у патогена не будет никаких шансов.
Питание при стафилококковой инфекции
Во время устранения стафилококковой инфекции, так же как и когда проводится лечение фурункула, какой-то определенной диеты самостоятельно придерживаться не стоит, поскольку организм каждого человека индивидуален в своих потребностях. За списком разрешенных продуктов нужно идти только к врачу.
Придерживаться нужно рекомендаций доктора, которые помогут сохранить здоровье и укрепить иммунитет во время борьбы организма с любым типом стафилококка:
- Употребляйте больше белков. Норма белков за одни сутки для среднестатистического человека составляет 80 грамм, и лишь 65% из них должны составлять белки животного происхождения. Особенно полезно употреблять такую пищу пациентам, которых постоянно мучает фурункулез – это одно из самых неприятных проявлений стафилококковой инфекции;
- Ешьте больше продуктов, содержащих углеводы. В течение суток в организм человека должно поступить 300 грамм углеводов, из них 200 грамм – сложные, а остальные 100 грамм – те, которые легко усваиваются;
- Пейте больше жидкости. Это поможет быстрее очистить организм от продуктов жизнедеятельности стафилококка и снизит уровень интоксикации;
- Употребляйте большое количество витаминов. Отличный способ поддержать иммунитет, что крайне важно во время борьбы со стафилококковой инфекцией;
- Пейте меньше кофе. Также это касается соленых блюд и продуктов с повышенным содержанием жира.
Вопрос-ответ
Как понять, что в кишечнике золотистый стафилококк?
Каковы признаки кишечного заражения золотистым стафилококком у взрослых? Основные признаки кишечного заражения: диарея, острая боль в животе, рвота и тошнота. Также может повыситься температура тела.
Как понять, что в горле золотистый стафилококк?
Першение в горле, болезненность при глотании, сухой кашель, тошнота, рвота, общее ослабленное состояние, сильные головные боли, приступы эпилепсии, сильная одышка, болезненные ощущения в суставах.
Какое самое эффективное лечение стафилококковой инфекции?
Для лечения стафилококковой инфекции применяют антибиотики нового поколения — полусинтетические пенициллины, аминогликозиды и некоторые другие. Также используют бактериофаги — специфические вирусы, которые прицельно уничтожают именно стафилококки.
Как можно заразиться золотистым стафилококком?
Заражение MRSA происходит в первую очередь контактно-бытовым путем, то есть от человека к человеку при непосредственном контакте в бытовой среде, а также при контакте с постельным бельем и одеждой. Бактерии могут долго жить в сухой пыли.
Советы
СОВЕТ №1
Регулярно проходите медицинские обследования и анализы, особенно если у вас есть предрасположенность к инфекциям. Это поможет выявить наличие золотистого стафилококка на ранних стадиях и предотвратить развитие серьезных заболеваний.
СОВЕТ №2
Обратите внимание на гигиену: мойте руки с мылом после посещения туалета и перед едой. Это поможет снизить риск заражения стафилококком и другими патогенными микроорганизмами.
СОВЕТ №3
Если у вас появились симптомы, такие как высокая температура, боль в горле или кишечные расстройства, не откладывайте визит к врачу. Раннее обращение за медицинской помощью может значительно упростить лечение и снизить риск осложнений.
СОВЕТ №4
Следите за своим иммунитетом: правильно питайтесь, занимайтесь физической активностью и избегайте стрессов. Сильная иммунная система поможет организму справляться с инфекциями, включая золотистый стафилококк.